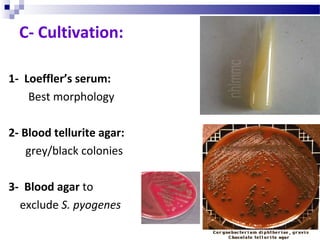
1- Loeffler’s serum:
Best morphology
2- Blood tellurite agar:
grey/black colonies
3- Blood agar to
exclude S. pyogenes
C- Cultivation:

This document discusses Gram positive bacilli including Corynebacterium and Listeria. It focuses on Corynebacterium diphtheriae, providing details on its morphology, culture characteristics, virulence factors causing diphtheria, clinical manifestations of disease, diagnosis and prevention through vaccination. It also briefly discusses Listeria monocytogenes and its ability to cause neonatal meningitis through contaminated food consumption by the mother.